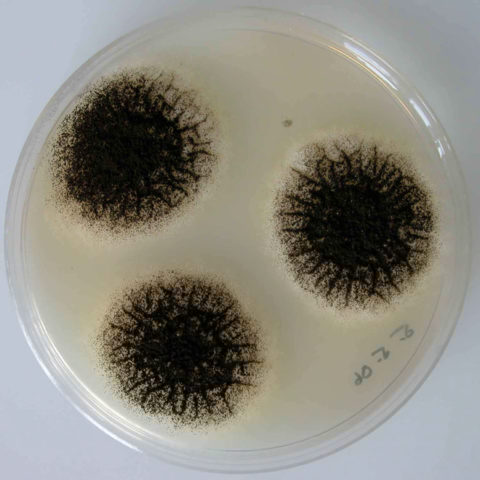

Nội dung
Kombucha hiếm khi bị mốc, nhưng nếu có thì tức là đã xảy ra lỗi. Có lẽ vấn đề vệ sinh, các quy tắc chăm sóc, sự lây nhiễm do côn trùng mang vào, hoặc chỉ là không khí bẩn bên trong phòng. Trong mọi trường hợp, bạn cần phải tìm ra nguyên nhân và loại bỏ nó.
Tại sao kombucha mọc mốc trong lọ
Một dấu hiệu cho thấy sức khỏe của kombucha là những con sứa nổi trên bề mặt chất lỏng bên trong lọ. Nếu nấm bị bệnh hoặc bắt đầu biến mất, nó sẽ chìm xuống đáy, nhưng không phải lúc nào cũng ngay lập tức. Lúc đầu có thể xuất hiện nấm mốc. Nó phát triển trên bề mặt của medusomycete, trong khi vẫn trôi nổi, tiếp xúc với không khí. Có nhiều nguyên nhân dẫn đến sự xuất hiện của bệnh, nhưng thường gặp nhất là do không khí bẩn có khói thuốc lá hoặc đồ uống làm lạnh dưới nhiệt độ cho phép 18 trong khoảngTỪ.

Sự xuất hiện của nấm mốc trên bề mặt thức uống cho thấy chè thạch rau câu đã hỏng.
Khi kombucha bị mốc, bạn có thể tiến hành hồi sức. Khu vực có nấm mốc được loại bỏ, rửa sạch sứa bằng nước ấm, ủ trong giấm táo qua đêm. Vào buổi sáng, sứa được đặt trong một lọ đã khử trùng, chứa đầy siro trà đã chuẩn bị với thêm 1 muỗng canh. l. Giấm.
Loại nấm mốc nào xuất hiện trong lọ kombucha
Nấm mốc rất ngấm ngầm, thậm chí có thể gây nguy hiểm cho sức khỏe. Nở hoa trắng được coi là an toàn nhất. Tuy nhiên, thường xuyên hơn không, khi thạch chè biến mất, có hai loại nấm mốc bám trên đó:
- Màu xanh lá cây nở đôi khi có sắc thái của màu xanh lam. Một loại nấm mốc nguy hiểm được gọi là "penicillum notatum".
- Mảng bám đen được hình thành bởi không ít loại nấm nguy hiểm “aspergillus niger”.
Nếu nấm mốc đen hoặc xanh lá cây với các sắc thái xanh lam đã hình thành trên kombucha, tốt hơn là nên loại bỏ nó và nuôi một con sứa mới.
Tại sao sự xuất hiện của nấm mốc trên kombucha lại nguy hiểm?
Nấm mốc tồn tại trong điều kiện xấu nhất. Bạn không thể loại bỏ chúng. Không hợp lý khi hồi sinh thạch trà, trên đó đã xuất hiện những bông hoa màu xanh lam, xanh lục hoặc đen. Thực tế không phải là sau khi rửa kombucha trong một lon mới, sứa sẽ không bị mốc. Bào tử nấm rất khó loại bỏ, những bào tử còn lại sinh sôi nhanh chóng.
Tuy nhiên, nếu kombucha đã bị mốc khi được trồng với một bông hoa màu trắng, thì nó rất đáng để lưu lại. Bạn có thể cố gắng hồi sinh kombucha bị nấm mốc xanh hoặc đen, nhưng ở giai đoạn đầu, khi các dấu hiệu đầu tiên xuất hiện.
Danh sách các lý do khiến kombucha bị mốc
Nguyên nhân chính dẫn đến tình trạng nấm mốc xuất hiện là do không tuân thủ công nghệ trồng chè thạch rau câu. Nếu chúng ta xem xét từng sắc thái riêng biệt, thì có khá nhiều trong số chúng.

Đầu tiên, nấm mốc xuất hiện trên bề mặt đồ uống thành những vòng tròn nhỏ, sau đó phát triển trên toàn bộ gương của chất lỏng
Vi phạm các quy tắc vệ sinh
Thường thì lý do chính khiến kombucha bị mốc là do điều kiện vệ sinh. Không nên để thức uống gần bát đĩa, rau, quả bẩn, nơi bảo quản thoáng, nơi tiếp xúc với vật nuôi. Khi rót đồ uống hoặc phục vụ thạch rau câu, hãy giữ cho tay của bạn sạch sẽ. Bàn, lọ, dao kéo được rửa sạch bằng nước nóng.
Vi phạm các quy tắc chăm sóc
Tốt nhất là chăm sóc medusomycete bằng găng tay cao su y tế. Chỉ có họ mới có thể cung cấp vệ sinh sạch sẽ. Điều này đặc biệt đúng với những phụ nữ có móng tay dài. Nhiều vi khuẩn gây bệnh tích tụ dưới móng tay, dẫn đến sự xuất hiện của nấm mốc. Trong trường hợp không làm móng lâu, có thể cấp phát găng tay, nhưng phải rửa tay bằng xà phòng diệt khuẩn. Ngay cả móng tay cắt ngắn cũng được làm sạch bằng bàn chải.
Vi phạm các quy tắc nấu ăn
Đồ uống kombucha được pha chế theo một công thức đơn giản. Nếu bạn không làm theo nó, nấm mốc xanh hoặc đen sẽ phát triển bên trong lọ thay vì kombucha. Khi mua trà về đổ lại, bạn không được lấy hàng cũ hết hạn sử dụng, hàng trong bao bì bị hỏng, bẩn. Bào tử của nấm mốc chắc chắn sẽ có bên trong. Điều quan trọng là phải sử dụng dao kéo sạch khi chuẩn bị đồ uống của bạn.
Không khí bị ô nhiễm
Nấm mốc luôn phát triển trong môi trường thuận lợi: không khí ẩm và ô nhiễm, nhiệt độ dưới + 18 trong khoảngC. Nếu bầu không khí như vậy được quan sát trong phòng, nấm nhất thiết sẽ bị mốc. Cấm hút thuốc bên trong phòng trà sứa. Khi phòng ẩm, trên thành bình có vết mốc, cổ lọ phải đậy bằng vải, nhiều lớp gạc hoặc khăn ăn. Điều quan trọng là phải giặt vỏ vải thường xuyên hơn, vì các bào tử nấm mốc tích tụ trên bề mặt của nó.
Nấu bia kém
Chè thạch rau câu dễ bị kém khi pha. Bạn không thể sử dụng các loại trà cũ, đặc biệt là những loại trà có hương vị với các tinh chất khác nhau. Dầu thơm góp phần hình thành nấm mốc bằng cách làm suy yếu hệ thống miễn dịch của kombucha. Ngoài ra, các loại trà này còn chứa một loại thuốc nhuộm có tác dụng tiêu diệt nấm.
Hàng xóm không mong muốn
Kombucha không thích gần động vật, chim chóc, bể cá, thức ăn và đồ dùng của vật nuôi. Bạn không thể đặt hoa gần lọ với thạch trà, cả bó hoa đã cắt và văn hóa trồng trong lọ hoa.
Phải làm gì nếu nấm mốc xuất hiện trên kombucha
Kombuchevodov đã nghĩ ra một số cách để cứu nấm khỏi mốc:
- Nếu nấm mốc xuất hiện trên bề mặt của kombucha, toàn bộ đồ uống từ lon sẽ bị đổ xuống cống. Sứa lấy ra khỏi thùng, dùng nước chanh tươi vắt thật sạch hoặc giấm rượu 10%. Kombucha được đặt trong một bình đã khử trùng, đổ với nước pha trà tươi, thêm 1-2 muỗng canh. l. Giấm.
- Khi cơ thể bị nấm mốc xanh hoặc đen, xuất hiện các đốm màu xanh, đỏ, tím thì những vùng này sứa đã bị loại bỏ. Kombucha được rửa kỹ bằng nước sạch. Tất cả các vùng lỏng lẻo của cơ thể được loại bỏ theo cùng một cách trong quá trình xả nước. Phần còn lại của nấm khỏe mạnh được cho vào lọ đã khử trùng, chứa đầy lá trà.
- Khi kombucha bị mốc, bạn có thể dùng giấm táo để hồi sức. Theo truyền thống, sứa đầu tiên được rửa bằng nước sạch. Các khu vực bị hư hỏng được loại bỏ. Nấm được cho vào bát đựng giấm táo nguyên chất, rửa thật sạch và dùng tay xoa đều axit lên thân nấm. Sứa trà được làm sạch lại được gửi vào một bình tiệt trùng, chứa đầy lá trà mới.

Sứa chè tốt cho sức khỏe luôn nổi trên bề mặt
Khi mức độ nhiễm nấm mốc lớn, không nên xử lý hồi sinh nấm. Tốt hơn để trồng một kombucha mới.
Tôi có thể uống đồ uống không nếu nấm mốc xuất hiện trên bề mặt của kombucha
Nấm mốc rất âm ỉ và nguy hiểm. Không thể uống một thức uống bị mốc. Tốt nhất, bạn có thể thoát khỏi tình trạng khó chịu đường tiêu hóa. Trong trường hợp xấu nhất, các phản ứng dị ứng, các dạng bệnh phức tạp của hệ tiêu hóa sẽ xuất hiện. Ở những biểu hiện đầu tiên của nấm mốc, toàn bộ đồ uống phải được đổ xuống cống.

Sự xuất hiện của một lớp màng mốc cho thấy đồ uống không phù hợp
Đôi khi bề mặt của nấm được phủ một lớp màu trắng nhạt. Nó thường bị nhầm lẫn với nấm mốc. Trên thực tế, vấn đề biểu hiện bằng việc sứa bị xả nước thường xuyên. Vào mùa hè, quy trình nên được thực hiện mỗi tuần một lần, và vào mùa đông - hai tuần một lần.
Các biện pháp phòng ngừa
Những người theo thuyết Kombuchevodists tuân thủ bảy quy tắc cơ bản để ngăn ngừa bệnh sứa:
- Nấm cần một vi khí hậu thuận lợi liên tục. Sứa được giữ trong chất lỏng có nhiệt độ từ 18 đến 25 trong khoảngC. Không đổ đầy nóng vào bình. Cổ luôn được thắt dây bằng vải thoáng khí.
- Nơi trong phòng đóng hộp được chọn ấm áp, tránh xa cửa sổ, bát đĩa bẩn, thực vật và vật nuôi. Ánh sáng mặt trời trực tiếp là không thể chấp nhận được.
- Nhiệt độ phòng không được xuống dưới 17 trong khoảngC. Trong điều kiện này, nấm không phát triển.
- Duy trì vệ sinh là một cách chắc chắn để thành công. Bạn không thể phục vụ thạch rau câu với bàn tay bẩn. Nước sôi ấm được dùng để rửa.
- Không thể chấp nhận được việc đổ đường chưa tan vào trong bình. Các hạt tạo thành vết bỏng trên cơ thể của kombucha.
- Luôn luôn để lại một ly chất lỏng bột chua từ thức uống đã cạn. Nó được đổ vào một trạm xăng mới.
- Quá trình lên men không được tăng lên. Thức uống hoàn thành phải được rút cạn kịp thời.
Tất cả bảy quy tắc đều đơn giản. Theo dõi chúng dễ dàng hơn là trồng lại nấm sau đó.

Tuân thủ các biện pháp phòng ngừa sẽ ngăn ngừa nấm mốc từ thức uống ngon và tốt cho sức khỏe
Từ video, bạn có thể tìm hiểu về cách trồng kombuchi:
Phần kết luận
Kombucha trở nên ẩm mốc thường xuyên hơn do lỗi của chính chủ sở hữu. Nếu bạn làm theo công nghệ trồng kombucha, những rắc rối có thể tránh được.